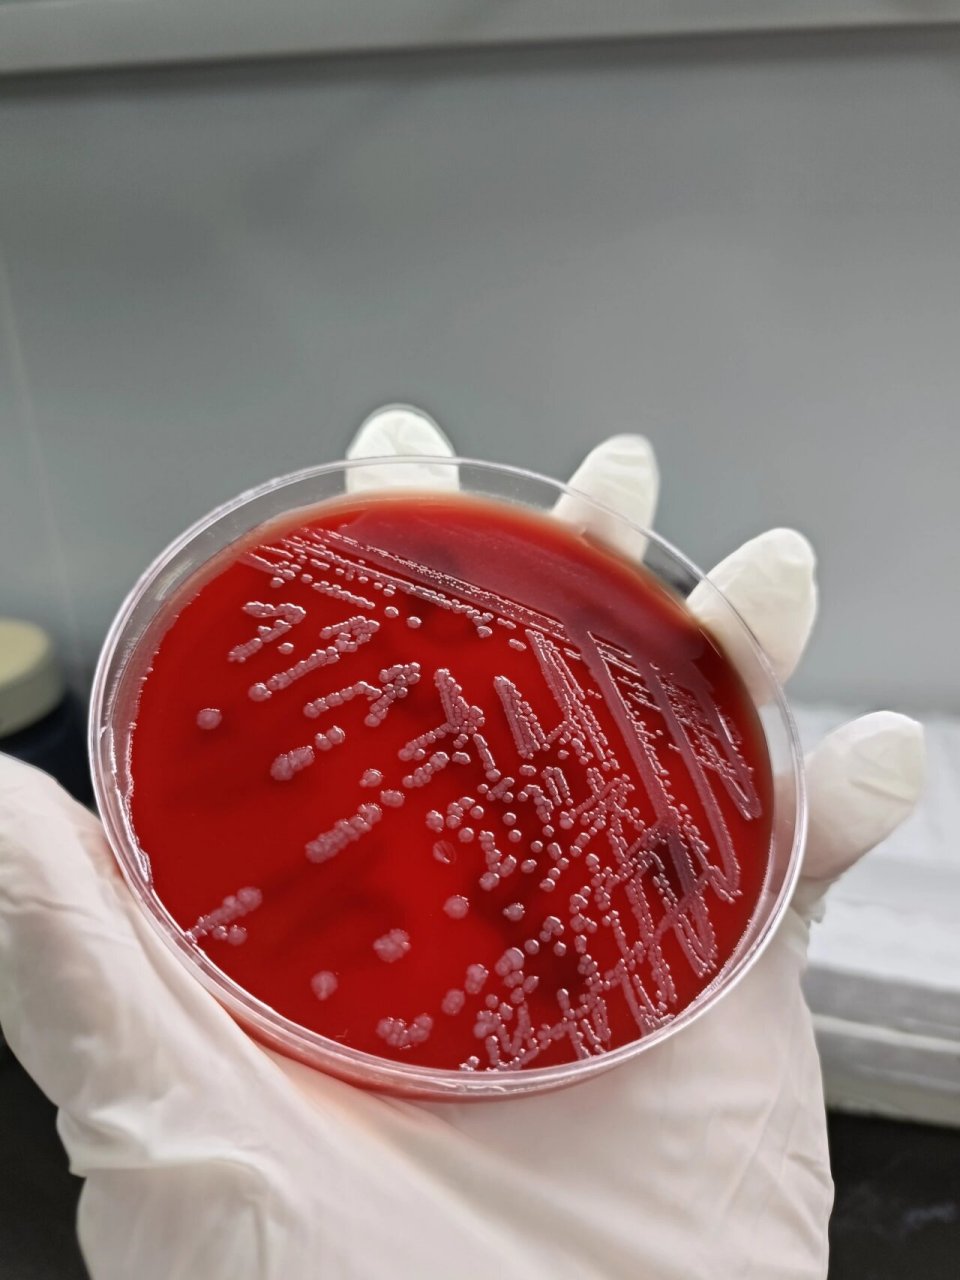
ecl 阴沟肠杆菌 革兰阴性菌 肠道的正常菌群 培养特性 不溶血湿润粘液

阴沟肠杆菌

上海交大科学家发现肥胖直接"元凶"阴沟肠杆菌
图片尺寸300x279
阴沟肠杆菌(阴沟肠杆菌阴沟亚种)规格
图片尺寸500x500
阴沟肠杆菌 来自竹子翠2012 - 微博
图片尺寸690x920
阴沟肠杆菌
图片尺寸400x327
阴沟肠杆菌
图片尺寸379x214
阴沟肠杆菌
图片尺寸2736x3648
阴沟肠杆菌阴沟亚种-安防展览网
图片尺寸365x272
ecl 阴沟肠杆菌 革兰阴性菌 肠道的正常菌群 培养特性 不溶血湿润粘液
图片尺寸960x1280
阴沟肠科杆菌第二天麦康凯培养皿
图片尺寸1080x1439
宗志勇教授团队在细菌耐药性研究中发现临床标本分离到的阴沟肠杆菌
图片尺寸516x390
一株蓝莓根际促生阴沟肠杆菌及其应用的制造方法与工艺
图片尺寸1000x652
阴沟肠杆菌及其用途的制作方法
图片尺寸1343x673
肠杆菌图片
图片尺寸450x300
中发现临床标本分离到的阴沟肠杆菌实际上绝大多数都不是阴沟肠杆菌
图片尺寸558x442
阴沟肠杆菌又会导致怎样的危害?可能会有哪些致病菌?
图片尺寸1080x608
阴沟肠杆菌
图片尺寸300x258
革兰氏阴性杆菌的简介
图片尺寸1024x768
革兰氏染色原理革兰氏染色原理革兰氏染色原理
图片尺寸585x417
爪哇根霉说明书
图片尺寸500x500
阴沟肠杆菌
图片尺寸300x224